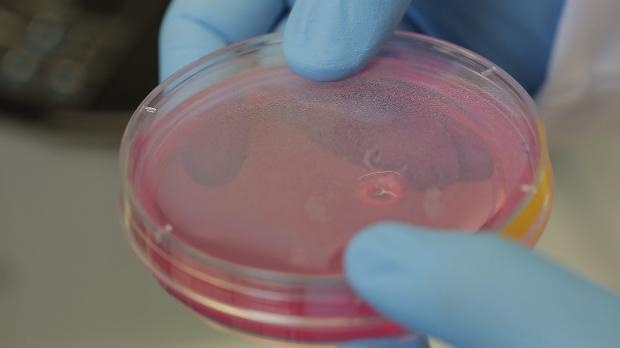
Türk doktorlar bir ilki başardı 5

Sabancı Üniversitesi Nanoteknoloji Uygulama ve Araştırma Merkezi’nde dünyanın ve Türkiye’nin ilk 3 boyutlu biyoyazıcı ve insan canlı hücreleri kullanılarak aort damarı üretildi. Üniversitenin Mühendislik ve Doğa Bilimleri Fakültesi Üretim Sistemleri Programı öğretim üyesi Doç. Dr. Bahattin Koç ve ekibi çatallanan damarları üretme çalışmaları da yapıyor.
Türk doktorlar bir ilki başardı
 116
116
 216
216
TUBİTAK’ın destek verdiği proje dün düzenlenen basın toplantısıyla paylaşıldı. Koç, yaklaşık 300 bin lira bütçeli projenin ve benzerleri çalışmaların yapay organ üretiminin adımlarından biri olduğunu söyledi. Koç aort ile başlamalarının nedenlerini şöyle sıraladı:
 316
316
“Aort damarı vücuttaki en büyük ve tek damar olduğu için vücudun başka yerinden alınacak damarla tedavisi mümkün değil.
 416
416
Şu anda tedavisinde sentetik damarlar kullanılıyor. Ama bunlar hiçbir zaman insanın kendi damarları gibi olmuyor. İkinci sebepse, 3 boyutlu yazıcıyla doku ve organ üreteceksek bu doku ve organların beslenmesi için öncelikle damar dokusunun oluşturulması gerekiyor. Bizim çalışmamız sonucunda, abdominal (karın) aort damarı hastanın kendi hücre veya kök hücrelerini kullanarak üretebilecek ve yapay damar bu tür hastalara nakledilebilecek. Şu anda yolun başındayız, hastalara uygulanması yıllar alabilir. Ancak ilaç sanayi için önemli bir aşama. İlaç denemelerini bu şekilde üretilen dokularda yapabilirler.”
516
516
Bilim adamı Einstein’ın ölüm sebebinin abdominal(karın) aort anevrizması olduğunu anlatan Koç, “Bizim çalışmamız sonucunda, abdominal aort damarı hastanın kendi hücre veya kök hücrelerini kullanarak üretilebilecek ve yapay damar bu tür hastalara nakil edilecek” dedi.
 616
616
Koç çalışmalarında, bugüne dek yapılan benzerilerinden farklı olarak 3 boyutlu basımda canlı hücreleri biyo-mürekkep olarak kullandıklarını söyledi. Sözkonusu biyo-mürekkebin satın alınan fibroblastların (bağ dokusunun ana hücreleri) çoğaltılmasıyla elde edildiğini belirten Koç, “Projenin ileriyi dönük en önemli hedefi 3 boyutlu biyo-yazıcıyla hastanın kendi normal hücrelerini ve kök hücrelerini kullanarak doku hatta organın birebir kopyasını üretmek.
 716
716
Bu doku ve organın vücut tarafından reddi sorunlarını ortadan kaldıracaktır.
 816
816
3 boyutlu yazıcıyla yumuşak dokular üretmek, kemik gibi sert dokulara göre çok daha zor. Ama biz yumuşak dokular üzerinde çalışmayı düşünüyoruz. Şu anda tam fonksiyonlu bir yapay doku üretme aşamasında değiliz ama bunun için çalışmalarımız devam ediyor” dedi.
 916
916
Bir aort 3 boyutlu yazıcıyla yaklaşık 1.5-2 saatte elde edilebiliyor. Üretim adım adım şöyle gerçekleşiyor: Aort damarı doku örneğinin MR (manyetik rezonans) taramasıyla dataları çıkarılıyor. Yine ekibin geliştirdiği algoritmalar kullanılarak üretilecek dokunun anatomisine göre hücrelerin basım yolları en uygun şekilde hesaplanıyor.
 1016
1016
Aynı zamanda hücreleri desteklemek için destek yapılar belirleniyor. Bu çalışmanın diğer yapılanlardan en büyük farkı, tüm hücrelerin tamamen birbirini desteklemiş şekilde dokunun üç boyutlu anotomisine uygun olarak belirlenmesi.
 1116
1116
Disiplinlerarası bir çalışmanın sonucu olarak üretim sistemleri, biyoloji, nanoteknoloji, malzeme, gibi konularda çalışan yüksek lisans öğrencileri ile araştırmacıların yer aldığı dört kişilik ekip, ayrıca biyoloji konusunda Yeditepe Üniversitesi ve tıbbi konularda GATA’daki danışmanlarından da destek alıyor. Öte yandan insan damar dokusu genel olarak üç farklı hücre tipinden oluşuyor. Bunlar fibroblast, endotel ve düz kas hücreleri. Fibroblast hücreleri bağ dokusunun ana hücreleri.
 1216
1216
Dokular için gerekli olan ekstraselüler matriks yapısının ve kolojen proteinin oluşumunu sağlıyor. Endotel hücreleriyse damarların ince iç tabakasını oluşturan hücreler. Düz kas hücreleri damar, yemek borusu, bağırsak gibi iç organlarda bulunan kas hücreleri.
 1316
1316
Bir sonraki aşama olarak fibroblastların yanı sıra endotel ve düz kas hücrelerini de kullanarak oluşturulacak damar dokusunu biyoreaktörde güçlendirmek için çalışmalar devam ediyor.
 1416
1416
Sabancı Üniversitesi Üretim Sistemleri Mühendisliği Programı Öğretim Üyesi Bahattin Koç’un 3B yazıcı ile üretim araştırmalarına yaklaşık 16 yıl önce başladı. Doku mühendisliği ile ilgili çalışmalarına Amerika’da University at Buffalo (SUNY) de yaklaşık 7 sene önce başladı.
 1516
1516
Amerikan Savunma Sanayi tarafından desteklenen yapay deri ve yaraların iyileşmesi için scaffold adı verilen 3 boyutlu destek yapılarının tasarımı ve üretimi üzerinde çalışmalar yaptı. Yaklaşık 2 yıldır da bu proje üzerinde çalışıyordu.
 1616
1616